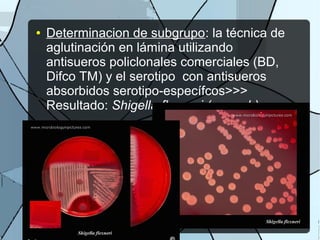
● Determinacion de subgrupo: la técnica de
aglutinación en lámina utilizando
antisueros policlonales comerciales (BD,
Difco TM) y el serotipo con antisueros
absorbidos serotipo-específcos>>>
Resultado: Shigella flexneri (grupo b)

Este documento presenta el caso clínico de un paciente VIH positivo de 42 años que acudió a emergencias con diarrea líquida y pérdida de peso de 20 kg en los últimos 4 meses. Los exámenes clínicos y de deposiciones revelaron la presencia de Shigella flexneri, confirmando el diagnóstico de bacteriemia. El paciente fue tratado con antibióticos y tuvo una recuperación favorable.